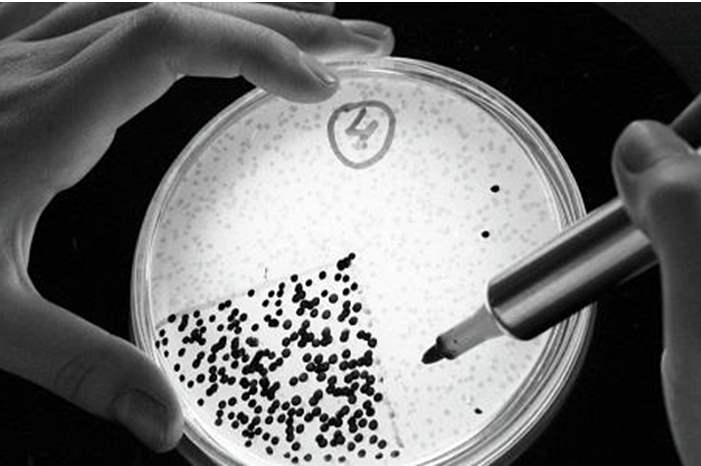
main_image5cac92b1b52e6

حذر خبراء من عدوى فطرية قاتلة لا يوجد أي دواء قادر على إيقافها، تجتاح العالم.
ووفقا لصحيفة "ذا صن"، يمكن للجرثومة المكتشفة حديثا، والتي تسمى "Candida auris"، أن تبقى على جلد الأشخاص والأدوات مثل الأثاث والمعدات في المستشفيات، لفترة طويلة، ما يجعلها تنتشر بشكل غير مباشر بين المرضى، وتحديدا الرضع والمسنين.
وما يثير القلق هو قدرة الجرثومة على مقاومة الفئات الرئيسة الثلاث من الأدوية المضادة للفطريات، ما يترك للأطباء خيارات علاجية قليلة.
وانتشرت العدوى في فنزويلا وإسبانيا، كما وصلت إلى بريطانيا في عام 2015، قبل أن يتم الإبلاغ عن 587 حالة في الولايات المتحدة.
اظهار أخبار متعلقة
وكشفت دراسة أن 45% من المرضى ماتوا خلال 90 يوما من تشخيص إصابتهم بالعدوى.
وتزداد خطورة العدوى الفطرية الجديدة، كون حامليها والمرضى بها لا يظهرون أي أعراض، ما يجعلها تنتشر دون علم.
ويعتقد خبراء أن الاستخدام المكثف للمبيدات الحشرية وغيرها من العلاجات المضادة للفطريات، تسبب في ظهور "Candida auris".